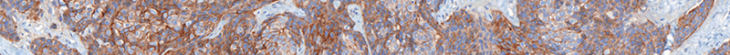

Q&A: Reflections on the 25 years of HER2 Targeted Therapy with Dr. Jan Trøst Jørgensen
As we enter October, the breast cancer awareness month, we had the privilege of sitting down with Dr. Jan Trøst Jørgensen to discuss the 25th anniversary of HER2 targeted therapy – a revolutionary approach that has transformed the landscape of breast cancer treatment.

Jørgensen holds a master’s degree in pharmaceutical science and a Ph.D. in clinical pharmacy from the University of Copenhagen. With 40 years of experience in research and development at various pharmaceutical, biotech, and diagnostic companies, including Novartis, Novo Nordisk, and Dako/Agilent, he has acquired extensive expertise in the field. Currently, he serves as the Director of the Dx-Rx Institute in Fredensborg, Denmark. Dr. Jørgensen is a strong advocate for individualized pharmacotherapy and has authored and edited numerous scientific papers on companion diagnostics, drug-diagnostic co-development, and precision medicine. Furthermore, he serves as an editorial board member for several medical journals and is a board member of the Danish Society of Cyto- and Histochemistry.
Dive into our enlightening conversation as we explore this milestone and its lasting impact on patient care.
Visiopharm: Welcome Jan, can you tell us a little bit about you and your background?
Jan Trøst: Certainly. My academic background includes an MSc in Pharmaceutical Science and a Ph.D. in Clinical Pharmacy. I have over 40 years of experience in clinical development encompassing both drugs and diagnostics, mainly in oncology. For the past 10-15 years, I have worked as an independent researcher at the Dx-Rx Institute, where I advise both pharmaceutical and diagnostic companies, engage in research, and have had the freedom to publish a number of scientific papers.
I have maintained a long-standing interest in companion diagnostics and have been involved in research in this field for many years. My interest in this area dates back 45 years to my lectures in basic pharmacology at the University of Copenhagen, where I was introduced to the concept of “rational use of drugs” or “rational pharmacotherapy.” This concept was already at that time translated as “the right drug to the right patient at the right time, in the right dose.,” However, it was easier said than done, due to the limited knowledge of pathophysiology and drug mechanisms of action at that time. However, with the advances in molecular medicine over the past 30-40 years, we have gradually begun to practice what was once known as rational pharmacotherapy, now referred to as precision or personalized medicine. This has been enabled in part by the development and use of new molecular diagnostic methods, including companion diagnostics.

Visiopharm: This year marks the 25th anniversary of HER2-targeted therapies. We have come a long way, haven’t we?
Jan Trøst: Yes, we have. The approval of the monoclonal antibody trastuzumab (Herceptin®) and the immunohistochemical assay HercepTest marked the beginning of a new era in treatment of cancer. This is the first time that we see a simultaneous approval of a drug together with a companion diagnostic assay. During the preclinical development of trastuzumab, a link between HER2 positivity and its tumor-inhibitory effect was discovered, and the subsequent parallel clinical development of drugs and diagnostic seemed obvious. Furthermore, as only 20% of women with breast cancer are HER2 positive, initiating treatment with trastuzumab without testing for HER2 has very little meaning.
“The approval of the monoclonal antibody trastuzumab (Herceptin®) and the immunohistochemical assay HercepTest marked the beginning of a new era in treatment of cancer.”
A few years after the approval of trastuzumab, the importance of the parallel drug-diagnostic development was emphasized by former ASCO president Gabriel Hortobagyi, who stated that without the assay, trastuzumab would likely have been dropped during clinical development due to insufficient efficacy in an unselected patient population. This was subsequently supported by a sample size calculation performed by the National Cancer Institute based on outcome data from the phase III trial of trastuzumab in patients with metastatic breast cancer. In this study, 469 HER2-positive patients were randomized and the trastuzumab group showed superiority over the chemotherapy group. These calculations by the National Cancer Institute showed that a similar study without testing for HER2 would have required more than 8,000 patients to reach the same efficacy outcome as that in the original phase III trial. Given my background in drug development, I strongly doubt that such a large-scale clinical trial would have ever been conducted.
This example emphasizes the significance of the drug-diagnostic co-development model and the clinical enrichment trial design. Using this design, patients are enrolled based on specific molecular tumor characteristics associated with the efficacy of the drug. By employing this type of design, the statistical power is increased, allowing meaningful clinical trials to be conducted in a relatively small number of patients. Consequently, drugs have been granted conditional approval by the FDA based on trials involving fewer than 100 patients, which was uncommon in the past. I think we can say that some of these drugs are standing on the shoulders of trastuzumab.
This year marks the 25th anniversary of HER2-targeted therapy. This is a significant milestone in the history of cancer treatment and one that we should celebrate. Trastuzumab, the first HER2-targeted therapy, was approved alongside the companion diagnostic assay, HercepTest, in 1998, which is another anniversary to celebrate this year. To describe this achievement, we in fact published an article in Frontiers in Oncology two years ago.

Visiopharm: What have been the primary challenges during these 25 years of HER2?
Jan Trøst: Cancer remains a life-threatening disease with significant unmet medical needs despite the progress made over the past 25 years. One of the challenges associated with cancer is its heterogeneous nature. For instance, lung cancer has traditionally been classified into two main groups based on its phenotypic characteristics (small-cell lung cancer and non-small-cell lung cancer). However, in recent decades, molecular medicine has revealed that lung cancer can be further divided into several subgroups based on their molecular characteristics. Along with this understanding, several drug-diagnostic combinations have been developed, enabling more effective treatment of patients with lung cancer.
“Cancer remains a life-threatening disease with significant unmet medical needs despite the progress made over the past 25 years.”
In general, the molecular classification of cancers has become increasingly important, and a few drugs with pantumor activity, are now classified as tissue agnostic, and for these drugs, it is a biomarker that solely determines their indication. A tissue agnostic drug refers to a drug that targets a specific molecular alteration across multiple cancer types, as defined by organ, tissue, or tumor type. For HER2, a drug such as trastuzumab deruxtecan (Enhertu®) also seems to possess pantumor activity and may likely in the future be classified as a tissue agnostic drug.
Development of drug resistance is another major challenge in cancer treatment. This phenomenon is commonly observed with most cancer drugs over time. However, increased attention is now being paid to understanding the mechanisms leading to drug resistance and to the development of drugs to counteract it. The ultimate goal is to find a cure for cancer; however, in the meantime, the objective is to manage cancer as a chronic condition. In this scenario, if a drug fails due to development of resistance, another drug can be used as a replacement that does not show cross-resistance with the previous.

Visiopharm: Can you discuss the challenges with HER2 interpretation?
Jan Trøst: Certainly. Breast and gastric cancer tissues possess intrinsic heterogeneity, with gastric cancer exhibiting the greatest degree of heterogeneity, which poses challenges and is the reason for the differences in HER2 scoring algorithms. Misinterpretation or discrepancies in scoring can lead to false-positive or false-negative test results, which can subsequently result in an incorrect treatment decision. It is important to keep this in mind that the reported test result can have significant implications for the patient. Several papers and results from proficiency testing have documented discrepancies in scoring between laboratories, which emphasizes the need for new tools and techniques that can improve accuracy and reproducibility. It is always important to keep in mind that what is done in the laboratory can have a direct impact on patient treatment and outcomes.
“Misinterpretation or discrepancies in scoring can lead to false-positive or false-negative test results, which can subsequently result in an incorrect treatment decision.“
“Several papers and results from proficiency testing have documented discrepancies in scoring between laboratories, which emphasize the need for new tools and techniques that can improve accuracy and reproducibility.“
Visiopharm: Why are low levels of HER2 clinically relevant now?
Jan Trøst: HER2-low is now relevant because a new antibody-drug conjugate, trastuzumab deruxtecan, has demonstrated efficacy in patients with metastatic breast cancer with low HER2 expression, defined as IHC1+ or IHC2+, and negative for HER2 gene amplification. Both the FDA and EMA have approved this indication based on data from the DESTINY-Breast04 trial, where trastuzumab deruxtecan demonstrated benefits over chemotherapy in terms of progression-free survival in patients with otherwise limited treatment options. However, the accurate identification of these patients is challenging. One of the challenges in assessing HER2-low status is that current IHC HER2 assays are not designed to distinguish low levels of HER2 expression. Recent data have shown a 41% discordance among pathologists in distinguishing between IHC0 and IHC1+. This is not sufficient, so there is room for improvement in both assay technology and training, potentially with the support of digital pathology tools.
“One of the challenges in assessing HER2-low status is that current IHC HER2 assays are not designed to distinguish low levels of HER2 expression. Recent data have shown a 41% discordance among pathologists in distinguishing between IHC0 and IHC1+.”
Visiopharm: Can you elaborate more on companion diagnostics?
Jan Trøst: Absolutely. Companion diagnostics belong to the group of predictive biomarkers. While there are various types of biomarkers, such as prognostic and diagnostic biomarkers, predictive biomarkers can predict the outcome related to a specific event, such as a pharmacological intervention. The FDA and EMA define a companion diagnostic as an in vitro diagnostic device that provides information that is essential for the safe and effective use of a corresponding therapeutic product. Companion diagnostic assays has demonstrated their value in both drug development and in the treatment of patients in clinical settings for the past 25 years. These assays play a crucial role, particularly in the case of cancer, where early diagnosis and early intervention are vital, and companion diagnostics help to select the right treatment. In the US, between 60 and 70 drugs or drug combinations have a companion diagnostic assay linked to their use, primarily in oncology and hematology. It is essential that the companion diagnostic assay is developed in parallel with the drug to obtain simultaneous regulatory approval, so it is available in the clinic to support patient selection. However, in recent years, targeted drugs have been approved without a companion diagnostic despite the use of a predictive biomarker assay during clinical development. This discrepancy prompted me to write an article addressing this concern, which was published in the Journal of Clinical Oncology Precision Medicine last year.
“It is essential that the companion diagnostic assay is developed in parallel with the drug to obtain simultaneous regulatory approval, so it is available in the clinic to support patient selection.“
The development of companion diagnostics has primarily been driven by genomic biomarkers, utilizing technologies such as in situ hybridization, polymerase chain reaction, and next-generation sequencing, which account for approximately 75% of the analytical platforms. The remaining 25% is covered by IHC . However, we might see a shift towards protein-based assays in the future. The complexity of the human molecular landscape is substantial, with approximately 22,000 coding genes and with an exponentially growing numbers in the transcriptome and proteome, with approximately 100,000 transcripts and 1,000,000 proteins, respectively. The National Cancer Institute has recently advocated for the integration of proteomics with genomic data, termed “proteogenomics,” to address the additional complexity that proteins and their post-translational modifications add, which are not fully captured by genomic data. Furthermore, proteins are the primary targets of pharmacological interventions.

Visiopharm: What should we expect in terms of future research in this area?
Jan Trøst: When it comes to drug targeting HER2, it looks interesting. A recent article published in Nature Review Drug Discovery discussed HER2 targeted therapy and its future direction and it looks like we should expect a lot. The drug pipelines across various pharmaceutical and biotech companies are brimming with innovations. In the years to come we will likely see the introduction of new monoclonal antibodies, bispecific antibodies, and newer antibody-drug conjugates like trastuzumab deruxtecan and trastuzumab emtansin. Additionally, new tyrosine kinase inhibitors, and therapeutic vaccines are also to be seen in the horizon.
“The drug pipelines across various pharmaceutical and biotech companies are brimming with innovations.”
HER2 targeted drugs are currently used to treat breast, gastric, and esophageal cancer, and recently also non-small cell lung cancer. However, HER2 overexpression is found in several other solid tumors, such as colorectal, bladder, cervical, and biliary tract tumors. Preliminary data from the DESTINT-PanTumor02 trial presented at the recent ASCO meeting showed high response rates, particularly in patients with IHC3+ tumors. Furthermore, a number of other trials with trastuzumab deruxtecan are currently ongoing in patients with different HER2 solid tumors; so, we might expect to see several new indications approved for HER2 targeted therapy in the future.
Visiopharm: How do you see the role of digital tools and AI in diagnostics and treatment?
Jan Trøst: With respect to the utilization of slide-based assays, I foresee a promising future for the integration of digital tools and AI. For IHC and ISH assays, several challenges exist, including issues related to reproducibility and repeatability. I am confident that the implementation of image analysis and AI will help to mitigate these concerns and improve the overall accuracy and reliability of these assays. I think we can say that digital pathology adds a new dimension to this type of assay. For companion diagnostics, incorrect test results can have significant implications on patient safety, and it is imperative to ensure the accuracy and reliability of these assays to avoid potentially harmful treatment errors.
“For IHC and ISH assays, several challenges exist, including issues related to reproducibility and repeatability. I am confident that the implementation of image analysis and AI will help to mitigate these concerns and improve the overall accuracy and reliability of these assays.”
Visiopharm: Thank you Dr. Jan Trøst for sharing your knowledge and experience with us in this insightful conversation.

Curious to learn more about Visiopharm’s AI-driven precision pathology solution for HER2?
Contact us here, and download our whitepaper to learn more about Visiopharm’s continuous scoring of the connectivity of the membranous HER2 staining.
Main references related to the interview with Dr. Jan Trøst Jørgensen
- Jørgensen JT, Winther H, Askaa J, Andresen L, Olsen D, Mollerup J. A Companion Diagnostic with Significant Clinical Impact in Treatment of Breast and Gastric Cancer. Front Oncol. 2021; 11: 676939. Read more
- Jørgensen JT. Twenty-five years with HER2 targeted therapy. Ann Transl Med 2023. doi: 10.21037/ atm-23-153. Read more
- Jørgensen JT, Hersom M. Clinical and Regulatory Aspects of Companion Diagnostic Development in Oncology. Clin Pharmacol Ther. 2018;103: 999-1008. Read more
- Jørgensen JT. The potential of trastuzumab deruxtecan as a tissue agnostic drug. Oncology. 2023. doi: 10.1159/000533866. Epub ahead of print. Read more
- Modi S, Jacot W, Yamashita T, Sohn J, Vidal M, Tokunaga E et al.; DESTINY-Breast04 Trial Investigators. Trastuzumab Deruxtecan in Previously Treated HER2-Low Advanced Breast Cancer. N Engl J Med. 2022; 387: 9-20. Read more
- Helwick C. Challenges of Accurately Identifying HER2-Low Breast Cancers. The ASCO Post. February 25, 2023. Read more
- Jørgensen JT. Oncology drug-companion diagnostic combinations. Cancer Treat Res Commun. 2021; 29: 100492. Read more
- FDA. List of Cleared or Approved Companion Diagnostic Devices (In Vitro and Imaging Tools). Read more
- Jørgensen JT. Missing Companion Diagnostic for US Food and Drug Administration-Approved Hematological and Oncological Drugs. JCO Precis Oncol. 2022; 6: e2200100. Read more
- Jørgensen JT. The current landscape of the FDA approved companion diagnostics. Transl Oncol. 2021; 14: 101063. Read more
- Rodriguez H, Zenklusen JC, Staudt LM, Doroshow JH, Lowy DR. The next horizon in precision oncology: Proteogenomics to inform cancer diagnosis and treatment. Cell. 2021; 184: 1661-1670. Read more
- National Cancer Institute. Molecular Diagnostics for Cancer Treatment: Completing the Picture. Read more
- Swain SM, Shastry M, Hamilton E. Targeting HER2-positive breast cancer: advances and future directions. Nat Rev Drug Discov. 2023; 22: 101-126. Read more
- Meric-Bernstam F, Makker V, Oaknin A, Do-Youn O, Banerjee SN, Martin AG, et al. Efficacy and safety of trastuzumab deruxtecan (T-DXd) in patients (pts) with HER2-expressing solid tumors: DESTINY-PanTumor02 (DP-02) interim results. J Clin Oncol. 2023;41 (suppl 17; abstr LBA3000). Read more